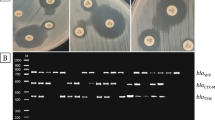

Abstract
Background
In the present study, we examine the prevalence of phylogenetic groups, O-serogroups, adhesin genes, antimicrobial resistance, the level of gene expression associated with biofilm formation, and the presence of extended-spectrum beta-lactamase (ESBL) in UPEC strains isolated from both pediatric and adult patients.
Methods
In this cross-sectional study, 156 UPEC isolates were collected from UTI patients. ESBL-producing isolates were detected using the double-disc synergy (DDS) method, and biofilm formation was assessed through a microplate assay. The presence of O-serogroups, adhesion factors and resistance genes, including ESBLs and PMQR genes, was detected by PCR, and isolates were categorized into phylogenetic groups using multiplex PCR. Additionally, the quantitative real-time PCR method was also used to determine the expression level of genes related to biofilm.
Results
During the study period, 50.6% (79/156) of the samples were obtained from children, and 49.4% (77/156) were from adults. The highest rate of resistance was to NA (91.7%), while FM (10.9%) had the lowest rate of antibiotic resistance. In addition, 67.9% (106/156) of UPEC isolates were ESBL producers. Most of UPEC isolates belonged to phylogenetic group B2 (37.1%). This study revealed that blaCTX-M and qnrS are widely distributed among UPEC isolates. The mean expression levels of fimA genes were significantly higher in non-biofilm producers than in biofilm producers (p < 0.01).
Conclusions
The high antibiotic resistance rates in this study highlight the significance of local resistance monitoring and investigating underlying mechanisms. Our findings indicate the dominance of phylogroup B2 and group D as the prevailing phylogenetic groups. Consequently, it is imperative to investigate the epidemiological aspects and characterize UPEC isolates across diverse regions and time frames.
Similar content being viewed by others
Avoid common mistakes on your manuscript.
Introduction
Uropathogenic Escherichia coli (UPEC) is the predominant cause of urinary tract infections (UTIs) and a common hospital opportunistic pathogen. UPEC has become one of the most challenging therapeutic problems due to the acquisition of plasmids encoding antibiotic resistance genes to β-lactams and quinolones [1, 2]. β-lactams and fluoroquinolones are extensively used to treat UTIs due to their efficacy, oral bioavailability, wide spectrum of action, and patient compliance.
However, the prevalence of multidrug-resistant (MDR) microorganisms has hindered the use of these antibiotics in recent decades [1, 3]. ESBL genes have also been discovered on a pathogen isolate's special plasmids, which encode plasmid-mediated quinolone resistance (PMQR) factors, including qnr, aac (6′)-Ib-cr, and qepA. Qnr proteins bind to bacterial DNA gyrase and topoisomerase IV to protect them from quinolones. Bacteria have qnr genes A, B, C, D, S, E, and VC. aac (6’)-Ib-cr and drug effluxes such qepA and oqxAB, are other PMQR determinants [3]. Mobile genetic elements such as conjugative plasmids, transposons, insertion sequences, and genomic islands can transfer antimicrobial resistance genes (ARGs) across E. coli strains. Recombination in E. coli strains is moderately caused by these components. However, E. coli populations are clonal and can be categorized into various phylogenetic groups [4, 5]. Phylotypes A, B1, B2, D, C, E, F, G, and the Escherichia cryptic clade I can be assigned to E. coli based on the presence or absence of four genetic sequences: chuA, yjaA, TspE4, and arpA [6]. E. coli strains are also classified by serological typing of their H (flagellar), O (lipopolysaccharide), and sometimes K (capsular) surface antigens. O1, O2, O4, O6, O7, O8, O15, O16, O18, O25, and O75 O-antigen types are typically expressed in UPEC clones [7].
Biofilm formation is a hallmark of opportunistic pathogens like UPEC. Bacterial cells adhered to biotic or abiotic surfaces form a biofilm. UPEC's biofilm mode produces many virulence factors (VFs) that aid biofilm cell adhesion to biotic or abiotic surfaces [8]. UPEC strains have evolved multiple fimbrial adhesins that assist them in colonizing the urinary tract [9]. Type 1 fimbriae consist of a major protein, FimA, and ancillary proteins, FimF, FimG, and the adhesin FimH, all of which are encoded by the fim gene cluster [10]. S and P fimbriae are expressed by the sfa operon and the pap gene cluster, which includes 11 genes (papA to papK). In conclusion, type 1 fimbriae cause UTIs by invading host cells, while P and S fimbriae facilitate infection [11]. Overall, the existence and expression levels of genes associated with biofilm formation determine the potential for biofilm formation.
Several studies in Iran and other countries have examined different characteristics in UPEC strains. Nevertheless, there has been a lack of comprehensive research investigating bacterial characteristics, including antibiotic resistance patterns, the distribution of β-lactamase and PMQR genes, phylogenetic groups, adhesion genes, O-serogroups, biofilm formation capacity, and biofilm-related gene expression levels in UPEC isolates from both children and adults with UTIs in northern Iran. This study fills a critical gap in research and illuminates UPEC-induced UTIs in this region and population.
Materials and methods
Study design and bacterial isolation
The study included 156 UPEC strains obtained from urine samples from 77 adults and 79 children who were admitted to hospitals affiliated with Babol University of Medical Sciences, north of Iran, during the period 2021–2022 [12].
The identification of the strains was accomplished by observing their colony morphology on eosin methylene blue (EMB) agar plates (Merck, Germany). The verification of lactose-fermenting colonies was performed through standard microbiological and biochemical tests, such as MR-VP, citrate, urease, nitrate reduction, motility at 37 °C, indole production, and gas production. Subsequently, a polymerase chain reaction (PCR) detection based on the uid gene for β-glucuronidase of E. coli was conducted to confirm the species [13]. Confirmed E. coli isolates were inoculated into brain heart infusion (BHI) broth containing 20% glycerol at 37 °C for 24 h, then stored at − 80 °C until further use.
Antimicrobial susceptibility testing (AST)
Antimicrobial susceptibility testing was conducted using the Kirby-Bauer disc diffusion method on Mueller–Hinton agar (Merck, Germany) following the guidelines established by the Clinical Laboratory Standards Institute (CLSI) [14]. The 16 antimicrobial drugs tested were: amoxicillin/clavulanic acid (AMC, 20/10 µg), ceftazidime (CAZ, 30 µg), cefixime (CFM, 5 µg), meropenem (MEN, 10 µg), trimethoprim-sulfamethoxazole (SXT, 1.25/23.75 µg), ciprofloxacin (CP, 5 µg), ofloxacin (OFX, 5 µg), nalidixic acid (NA, 30 µg), norfloxacin (NOR, 10 µg), nitrofurantoin (FM, 300 µg), gentamicin (GM, 10 µg), amikacin (AN, 30 µg), cefazolin (CZ, 30 µg), ceftriaxone (CRO, 30 µg), cefotaxim (CTX, 30 µg), and ampicillin-sulbactam (SAM, 20 µg) (Padtan Teb, Iran). The resistance score (RS) was determined based on the number of antibiotics to which an isolate demonstrated resistance [15]. Additionally, isolates demonstrating resistance to at least one agent in at least three antimicrobial categories were classified as MDR [16].
Detection of ESBL-producing E. coli
To detect ESBL production, ceftazidime (30 µg/mL) and cefotaxime (30 µg/mL) were used both with and without clavulanic acid (10 µg/mL). A positive result for ESBL production was identified as an increase of 5 mm or more in the zone diameter when clavulanic acid was present [9]. E. coli ATCC 25922 and Klebsiella pneumoniae ATCC 700603 were used as negative and positive control strains, respectively.
Biofilm formation assay
Biofilm formation by UPEC strains was tested using the microtiter plate assay as previously described [17]. The optical density (OD) of stained adherent biofilm was measured using an ELISA autoreader (Bio-Rad, USA) at a wavelength of 570 nm. The experiment was performed in triplicate and repeated three times. The data were interpreted based on the criteria proposed by Stepanović et al. [17].
Detection of UPEC serogroups, VFs, and antibiotic resistance genes
Genomic DNA was extracted from fresh colonies as described previously [18]. The purity and concentration of the isolated DNA were determined using a NanoDrop spectrophotometer (Thermo Scientific Wilmington, USA). Isolates were screened for the presence of O-serogroups (O1, O15, O16, and O25) and VFs, including fimH, fimA, pap, and sfa genes. Moreover, isolates harboring resistance determinants, including ESBLs (blaTEM, blaSHV, and blaCTX-M) and PMQR genes (qnrA, qnrB, and qnrS) were detected by PCR.
PCR amplification was carried out using a 12 μL mixture, which included 5 μL of pre-made MasterMix (AMPLIQON, Denmark), 5.2 μL of DNase-free distilled water, 0.3 μL of each primer (at a concentration of 10 pmol/μL), and 1.2 μL of the DNA template. The selection of target genes and the nucleotide sequences of the oligonucleotide primers adhered to previously described protocols [19]. The PCR thermal conditions are detailed in Table S1. The resulting PCR products were resolved on a 1.5% agarose gel prepared in 1X TBE (Tris/Borate/EDTA) buffer, and then visualized under ultraviolet light following staining with SafeStain loading dye (CinnaGen Co., Iran). Moreover, sequences of the O1, O15, O16, O25 serotypes, and the qnrB and qnrS genes were deposited in the NCBI database with the accession numbers OQ469818, OR826277, OQ469820, OQ469819, and OQ469817, along with OR826276 (https://www.ncbi.nlm.nih.gov/nuccore/OQ469818.1, https://www.ncbi.nlm.nih.gov/nuccore/OR826277.1, https://www.ncbi.nlm.nih.gov/nuccore/OQ469820 , https://www.ncbi.nlm.nih.gov/nuccore/OQ469819, and https://www.ncbi.nlm.nih.gov/nuccore/OQ469817, as well as https://www.ncbi.nlm.nih.gov/nuccore/OR826276.1).
Phylotyping of UPEC by quadruplex PCR
All UPEC isolates were assigned to phylogenetic groups according to the new method of Clermont et al. [6]. Multiplex PCR was performed using 12 μl reactions containing 5 μL of MasterMix (AMPLIQON, Denmark), 4.2 μL of DNase-free distilled water, 0.2 μL of each primer (10 pmol/μL), and 1.2 μL of DNA template. Gene amplification was achieved using the following thermal cycling protocol: an initial denaturation step of 5 min at 94 °C, followed by 30 cycles, each comprising 30 s at 94 °C, 30 s at 57 °C, and 30 s at 72 °C. The process was concluded with a final extension step of 5 min at 72 °C. Subsequently, the PCR products were subjected to electrophoresis on a 1.5% agarose gel that was stained with SafeStain loading dye (CinnaGen Co., Iran). Visualization was achieved by exposing the gel to ultraviolet light.
Quantitative real-time PCR (qRT-PCR) assay
QRT-PCR was used to examine the transcriptional expression of genes associated with type I fimbriae (fimA and fimH) in UPEC isolates positive for both ESBL and blaCTX-M, with or without biofilm formation. Therefore, these isolates underwent RNA extraction and genomic DNA removal using an RNeasy Mini kit (Viragene Akam Co.). Each RNA extract was adjusted to a final concentration of 150 ng/μL. Following the manufacturer's instructions, the RNA was reverse-transcribed into cDNA using a High Capacity cDNA Reverse Transcription Kit for single-stranded cDNA synthesis (Parstous Co.), and all the cDNAs were stored at -20 °C. The real-time PCR amplification reaction was prepared in a total volume of 25 µL, comprising 2.5 µL of cDNA, 12.5 µL of RealQ Plus Master Mix Green from Ampliqon in Denmark, 1 µL each of forward and reverse primers (each at a concentration of 10 nM), and RNase- and DNase-free water adjusted to a final volume of 25 µL. The primer sequences used for this analysis can be found in Table S2. To normalize gene expression, the d-glyceraldehyde-3-phosphate dehydrogenase A (gapA) gene was used as an internal control. Real-Time PCR was performed as follows: one cycle of initial denaturation at 95 °C for 15 min, followed by 40 cycles of denaturation at 95 °C for 15 s, annealing at 56, 51, and 49 °C for fimA, fimH, and gapA, respectively, for 30 s, and extension at 72 °C for 30 s. Expression levels of each gene in the clinical strains are presented as fold changes compared to transcript levels in E. coli ATCC 25922. These changes were determined using the 2-ΔΔCt method.
Statistical analysis
Statistical analysis was conducted using IBM Corp.'s SPSS™ software, version 16, located in the United States. Categorical variables were presented as frequencies and percentages. To assess significant differences, Fisher's exact test or the Chi-square (χ2) test was employed. A P value less than 0.05 was considered indicative of statistical significance. Continuous variables, such as antibiotic resistance scores, were compared between groups using one-way analysis of variance (ANOVA), followed by pairwise comparisons conducted using the Gabriel post hoc test.
Results
Demographic information of the participants
During the study period, 50.6% (79/156) and 49.4% (77/156) of UPEC isolates were obtained from children and adults, respectively. Moreover, 74.4% (116/156) and 25.6% (40/156) of UPEC isolates were obtained from female and male patients, respectively. All UPEC strains were isolated from inpatients diagnosed with UTI. The age range of the study group was from less than 1 year to 80 years old.
Phenotypic antimicrobial resistance of UPEC isolates
The antibiotic susceptibility pattern revealed varying frequencies of antibiotic resistance among the 156 UPEC isolates. Specifically, 99.4% (155/156) of the isolates exhibited resistance to at least one or more antibiotics. Notably, the highest resistance rate was observed against NA (91.7%), followed by SXT (74.4%). In contrast, FM (10.9%) and MEN (14.1%) exhibited the lowest rates of antibiotic resistance. Based on the study by Magiorakos et al. in 2012, the prevalence of MDR isolates was 88.5% (138/156). The total resistance rates of UPEC strains to quinolone antibiotics were as follows: NA (91.7%, 143/156), CP (66%, 103/156), OFX (48.7%, 76/156) and NOR (59%, 92/156). Based on ESBL screening test, 67.9% (106/156) of UPEC isolates were ESBL producers.
Further analysis revealed that all ESBL-positive strains (106 isolates) were resistant to CAZ and CTX, followed by NA (91.5%, 97/106), while MEN (4.7%, 5/106) and FM (7.5%, 8/106) were the most effective antibiotics against ESBL-positive isolates.
Out of non-ESBL isolates (50 isolates), the highest resistance rate was to NA (92%, 46/50), followed by SXT (78%, 39/50), while the most effective antibiotic was CAZ (12%, 6/50) and CTX (12%, 6/50). Furthermore, ESBL-producing isolates exhibited a higher resistance rate than non-ESBL-producing isolates against CTX (100% vs. 12%, P < 0.001), CAZ (100% vs. 12%, P < 0.001), and CRO (56.6% vs. 38%, P < 0.001). While, among non-ESBL-producing isolates, the resistance rates to MEN (34% vs. 4.7%, P < 0.001), FM (18% vs. 7.5%, P = 0.05), and GM (34% vs. 13.2%, P = 0.002) were significantly higher compared to ESBL-producing isolates, which is a rather strange finding. The complete antibiotic resistance patterns for both ESBL-negative and positive isolates are shown in Fig. 1.
Antibiotic resistance profile, resistance genes, O-serogroups, biofilm formation of uropathogenic Escherichia coli isolates, sorted based on ESBL phenotype. AMC amoxicillin/clavulanic acid, CAZ ceftazidime, CFM cefixime, MEN meropenem, SXT trimethoprim-sulfamethoxazole, CP ciprofloxacin, OFX ofloxacin, NA nalidixic acid, NOR norfloxacin, FM nitrofurantoin, GM gentamicin, AN Amikacin, CRO ceftriaxone, CTX cefotaxim, SAM ampicillin-sulbactam
Presence of β-lactamase genes
Out of 156 UPEC isolates, blaCTX-M (72.4%) was the most predominant gene, followed by blaTEM (43.6%) and blaSHV (7%). Additionally, 2.6% (4/156) of isolates had three ESBL genes, while 18.6% (29/156) had both blaCTX-M and blaTEM, 11.5% (18/156) had both blaCTX-M and blaSHV, and 2.6% (4/156) had both blaTEM and blaSHV simultaneously. Moreover, among non-ESBL isolates, the frequency of the blaSHV gene was significantly higher than in ESBL isolates (7% vs 4%, P < 0.02).
Presence of PMQR genes
PCR amplification of the PMQR genes revealed that 42.9% (67/156) of the isolates harbored at least one PMQR gene, with the following distributions: 37.2% (58/156) for the qnrS gene (38.7%; 41/106 ESBL-positive and 34%; 17/50 ESBL-negative), and 10.3% (16/156) for qnrB (9.4%; 10/106 ESBL-positive and 12%; 6/50 ESBL-negative). However, none of the isolates harbored the qnrA gene. Also, 3.8% (n = 6/156) of isolates harbored both qnrB and qnrS simultaneously.
There was no significant relationship between the distribution of qnrS and qnrB genes in ESBL-negative and positive isolates (P = 0.57 and P = 0.62). However, among ESBL-positive isolates, the qnrS gene was found to be relatively more prevalent than in ESBL-negative isolates, while compared to ESBL-positive isolates, the qnrB gene was detected to be relatively more common in ESBL-negative isolates (Fig. 1). moreover, the distribution of qnr genes among UPEC isolates obtained from both adults and children is presented in Table 1. The proportion of qnrS and qnrB genes among adults compared to children was relatively high, but the differences were not statistically significant. Additionally, Table 2 presents the relationship between resistance to quinolone antibiotics and the distribution of qnr genes.
Phylogenetic analysis
Based on the quadruplex PCR assay findings, a total of 137 out of 156 UPEC isolates were assigned to 7 of the 8 phylogenetic groups, and the results are presented in Table 3. The majority of UPEC isolates belonged to phylogenetic group B2, accounting for 37.1% of the total sample, followed by groups D, A, and E (12.8%), group F (6.4%), and B1 (5.1%). Notably, none of the isolates tested positive for phylogenetic group C. Among the remaining isolates, 12.1% were found to be untypeable.
Following group B2, phylogenetic groups A and D exhibited a higher prevalence among the isolates from children, whereas in adults, following group B2, groups E, A, and D were more commonly observed. However, no significant difference was noted between the two groups regarding phylogenetic distribution.
Moreover, except for phylogenetic group A and F, the proportion of B2, B1, D and E were more prevalent in ESBL-producing isolates. However, the statistical analyses did not reveal any significant correlation between ESBL-producing isolates and phylogenetic groups.
Antimicrobials resistance according to phylogenetic group
Phylogenetic groups showed variations in terms of antibiotic susceptibility patterns. The most resistant phylogroup was phylogroup A (RS median 9; range 5–15), followed by phylogroup B2 (RS median 8; range 2–14) and D (RS median 9; range 2–11), while the most susceptible phylogroup was phylogroup B1 (RS median = 6; range 0–8). Resistance to MEN and FM was not reported in phylogroup B1. Moreover, the statistical analyses reveal a significance association between the phylogenetic groups and antibiotic resistance score (P = 0.032). The median RS decreased progressively from a high of 9 (RS mean: 8.9, range 5–15) for phylogroup B2 isolates to a low of 6 (RS mean: 5.37, range, 2–9) for phylogroup B1 isolates. Also, based on Tables 4 and 5, among the adult isolates, phylogenetic groups A and B2 had the highest RS, while in the children’s isolates, the highest RS was associated with phylogenetic groups A and D.
Β-lactamase, PMQR, adhesion, and O-serogroups genes according to phylogenetic group
The blaCTX-M gene was found to be more prevalent in phylogroups B2 (75.9%) and E (75%). The presence of the blaTEM gene was significantly associated with phylogroup D compared to other phylogroups (P = 0.007). In this regard, both adult and children isolates follow this pattern as well. qnrS and qnrB were more frequently found in phylogroups D and F, respectively. The carriage of qnrS and qnrB was not significantly associated with different phylogroups.
Regarding the phylogroups, as shown in Table 3, the prevalence of pap was higher in phylogroups D (60%), followed by B2 (37.9%), whereas the frequency of sfa was more prominent in phylogroup B2 (48.3%) and F (30%). Moreover, isolates belonging to phylogroup B2 carried the sfa gene more frequently than strains belonging to the other phylogroups (P= 0.031). Regarding the distribution of O-serogroups in different phylogroups, a significantly higher frequency of O25 was detected among members of B2 than in other phylogroups (P < 0.001). Furthermore, O16, O1, and O15 were more frequent in B1, B2, and D phylogroups, respectively. However, Tables 4 and 5 show the serogroup distribution within the phylogroups of the UPEC strains isolated from adults and children.
Association between biofilm formation with phylogenetic groups, O-serogroups and resistance genes
The biofilm-producing strains were predominantly clustered in phylogenetic groups B1 and B2. On the other hand, the majority of the weak biofilm-formers and moderate biofilm-formers strains belonged to phylogroup B2 (Table 3). On the other hand, no statistically significant difference was observed between biofilm formation capacity and both phylogenetic groups and ESBL production (Fig. 2). Additionally, Table 6 displays the relationship between antibiotic resistance patterns and biofilm formation, and Table 7 illustrates the connection of biofilm with VFs, O-serogroups, and resistance genes.
Biofilm formation, according to phylogenetic group and ESBL production. Results are expressed as scatter plots, where bars indicate median values with interquartile range. Each dot is the average from two independent experiments with eight replicates of each strain per experiment. P < 0.05, ANOVA + Tukey's multiple comparison post-test
Expression levels of the genes involved in biofilm formation
To determine the expression levels of the genes involved in biofilm formation, we analyzed the expression level of each of the genes involved in biofilm formation in UPEC strains compared with those in E. coli ATCC25922 strains by real-time PCR. According to these results, the mean expression levels of fimA genes were significantly higher in non-biofilm producers than in biofilm producers (P < 0.01). A significant correlation was observed between the increased expression of the fimH gene and the ability to form biofilms (p=0.004) (Fig. 3).
Discussion
UPEC cause UTIs in both children and adults, but significant differences exist [20]. In children, particularly in infants and young children, UTIs are more prevalent due to anatomical and physiological factors. On the other hand, UTIs in adults, especially the elderly, may have different risk factors and clinical presentations, including underlying medical conditions and compromised immune system [21].
This is the first study comparing UPEC isolates from children and adults with UTI in northern Iran to examine factors such as antibiotic resistance patterns, distribution of β-lactamase and PMQR genes, phylogenetic groups, adhesion genes, O-serogroups, biofilm formation capacity, and gene expression levels (genes associated with biofilm formation). In this study, a total of 156 confirmed UPEC isolates were analyzed, with an approximately equal distribution between children (50.6%) and adults (49.4%).
UPEC isolates were more prevalent in women, accounting for a total of 116 cases, representing 74.4%. This finding is consistent with several previous studies [22,23,24] and supports the notion that sex plays a crucial role in the prevalence of UTIs, as reported by Rahn [25]. Furthermore, the prevalence of UPEC isolates in hospitalized patients with UTIs corresponds to the well-established understanding that UTIs are a frequent nosocomial infection [26].
The high prevalence of antibiotic resistance among UPEC isolates is a major concern in clinical practice, particularly in developing countries. This issue arises from factors such as the widespread availability of antibiotic drugs, overprescribing, and indiscriminate use of antibiotics [27]. In this study, the majority of the isolates exhibited significant resistance to a wide range of tested antibiotics, with 88.5% of strains demonstrating an MDR phenotype. This high prevalence of MDR strains underscores their role as a leading causative agent of a significant health issue in our area, which aligns with findings reported in previous studies conducted in various regions [28,29,30]. Additionally, this highlights the immediate requirement for the careful utilization of antibiotics and the development of alternative strategies to address the treatment of UTIs caused by MDR-UPEC strains.
Our study revealed that the isolates displayed the highest resistance to NA (91.7%), followed by SXT (74.4%), and the lowest resistance to FM (10.9%) and MEN (14.1%). These findings are consistent with previous reports on UPEC resistance worldwide [12, 31,32,33]. For example, in a comprehensive study conducted in Iran, Gharavi et al. demonstrated that UPEC had low resistance rates against MEN, AN, and FM [34]. Therefore, the use of NA for the treatment of UPEC in this particular region may not be effective. Conversely, FM and carbapenem drugs such as MEN are considered more favorable choices for the initial treatment of UTIs. Additionally, the study's discovery of low resistance to FM may be attributed to its infrequent use in standard UTI treatments.
Previous studies have reported a high prevalence of quinolone resistance in Iran. In this regard, most of the isolates were resistant to all the fluoroquinolone-containing antibiotics, a finding consistent with prior research conducted in Iran [1, 23]. However, notably, resistance to NA exceeded that observed for CP, OFX, and NOR. This discrepancy could potentially be attributed to the prolonged utilization of NA in the studied region, spanning a period of over five decades.
In a meta-analysis study conducted by Moghaddam et al., the resistance rates of quinolone agents, NA and CP, among UPEC strains were reported to be 68.4% and 61%, respectively [35].
Jomehzadeh et al. [1] demonstrated that among UPEC strains, resistance rates to NA, CP, OFX, gatifloxacin, levofloxacin, and moxifloxacin were 71.9%, 61.4%, 50%, 34.2%, 34.2%, and 29.8%, respectively, in a teaching hospital located in southwest Iran. Our study's findings were in agreement with these results [1]. In light of the high fluoroquinolone resistance rates observed in children, Akgoz et al. recommended avoiding the prescription of these antibiotics in pediatric populations and uncomplicated cases [36].
Furthermore, several observations have indicated that the emergence of quinolone resistance and the spread of resistance genes could potentially be attributed to the transmission of bacteria from animals to humans. This transmission pathway involves the consumption of poultry and meat products, which, in turn, can be associated with the improper use of antibiotics within the livestock industry [37].
According to our findings, 67.9% of the isolates exhibited the production of ESBLs. A meta-analysis conducted in Iran from 2008 to 2018 reported a substantial proportion of UPEC isolates (43.2%) being phenotypically identified as ESBL producers [38]. Moreover, higher prevalence rates of ESBL-producing UPEC strains have been documented in other regions, such as Shiraz [39], Rasht [40, 41], and Isfahan [42].
This heightened frequency may indicate an increasing trend of ESBL-producing strains over time. The elevated prevalence of ESBL-producing E. coli in Iran and other developing countries contrasts with the rates observed in developed countries such as Denmark (1.5%) [43], Germany (8.0%) [44], and the United States (7% to 15%) [45]. This difference can potentially be attributed to the extensive utilization of β-lactam drugs as the primary treatment for UTIs and the absence of stringent policies regarding antibiotic consumption and prescription in these regions. Regrettably, in Iran, there has been insufficient focus on antimicrobial screening programs, resulting in infections caused by bacterial strains that are resistant to multiple drugs being one of the leading factors contributing to illness and death among patients. In Iran, there are currently no clear protocols for controlling ESBLs.
Moreover, there was variation in the susceptibility patterns of drugs between ESBL-positive and ESBL-negative isolates. ESBL-positive strains exhibited a high level of susceptibility to MEN and FM, whereas ESBL-negative isolates showed a more favorable response to CAZ and CTX. This unexpected result suggests the presence of other resistance mechanisms or genetic factors contributing to the higher resistance rates in non-ESBL-producing isolates. The prevalence of antibiotic resistance, particularly ESBL, is higher in developing countries compared to developed nations due to the socioeconomic status of the society and the availability of antibiotics, which leads to self-medication, consumption of counterfeit drugs, improper dosage, and no adherence to antibiotic therapy. Therefore, the findings of this investigation highlight the urgent need for proactive surveillance systems to monitor the emergence and dissemination of ESBL in our region, given the high prevalence observed.
PMQR genes, including qnr, have been studied extensively in Iran. However, there is a lack of well-known reports that specifically address the molecular detection of PMQR determinants in UPEC, particularly in northern Iran. Regarding PMQR genes, our study identified a significant proportion of isolates carrying at least one PMQR gene, primarily qnrS followed by qnrB. This finding is consistent with previous reports that emphasize the involvement of qnrS and qnrB in quinolone resistance among UPEC isolates. In line with our findings, Sadeghi et al. [7] and Rezazadeh et al. [46] have also reported the absence of qnrA genes in their isolates. However, variations in the prevalence of the qnrA gene have been observed across different studies, indicating the need for further research to better understand the regional and temporal dynamics of these resistance determinants. Additionally, our results reported that 3.8% of isolates harbored both qnrB and qnrS simultaneously.
The findings revealed a high prevalence of blaCTX-M and blaTEM genes, while blaSHV exhibited a lower frequency. Importantly, meta-analytic studies conducted in diverse regions of Iran have consistently reported a relatively high prevalence of ESBL genes, which aligns with our results [38, 47]. Comparable to our investigation, other studies have found a high occurrence of blaCTX-M and blaTEM-positive isolates in various countries and regions, including northern and eastern Europe [48]. However, our study showed a higher prevalence of these genes compared to studies conducted in South Africa and Nigeria [49, 50]. Interestingly, a higher frequency of the blaSHV gene was observed among non-ESBL isolates in comparison to ESBL isolates. This finding contradicts certain previous studies [51, 52] that reported a higher prevalence of blaSHV in ESBL isolates. The variation in the distribution of genes highlights the dynamic nature of β-lactamase genes among different UPEC populations, emphasizing the necessity for ongoing monitoring and surveillance.
Furthermore, the distribution of qnrS and qnrB genes was analyzed in relation to ESBL status and age group, but no significant correlation was observed. This suggests that the mechanisms responsible for qnr genes and ESBL production may act independently. Additionally, the age group did not demonstrate a significant impact on the distribution of these genes.
Phylogenetic analysis indicated that the most frequently observed phylotype was B2, followed by D = A = E > F > B1 > C, respectively. These findings are consistent with previous studies conducted in Iran [53, 54] as well as other countries, including Ethiopia [55], Pakistan [56], China [57], and India [58], which also reported B2 as the predominant phylogroup, followed by D. However, an intriguing contrast was observed in a study conducted by Mohsin et al. [59] in Iraq, where phylotype F emerged as the most frequent, followed by C, B2, E, A, D, and B1, respectively [59]. While there is some variation, the prevailing trend across multiple studies supports the predominance of the B2 and D phylotypes in UPEC populations.
The differences in the prevalence of phylogenetic groups may be due to various factors such as genetic traits of the host, the location of the infection, the geographical area, the methodology used, the origin of the isolates, and differences in the sample size. In contrast, this study identified significant variations in antibiotic resistance patterns among different phylogenetic groups. Phylogroup A displayed the highest RS, followed by B2 and D, whereas phylogroup B1 exhibited the lowest RS. These findings suggest a correlation between phylogenetic group and antibiotic resistance, supporting the notion that phylogenetic group contributes to the development of antimicrobial resistance [60]. The post hoc analysis indicated a significant difference in RS between phylogenetic groups A and B1, with RS significantly higher in phylogroup A compared to B1 (P = 0.032). The elevated RS in phylogroups A, B2, and D further underscores the challenges in treating infections caused by strains belonging to these groups.
Our findings revealed that 64.1% of UPEC isolates exhibited biofilm-producing ability, with a majority of them belonging to phylogenetic groups B1 and B2. However, no significant association was found between biofilm formation and phylogenetic groups. The previous literature has reported an association between biofilm-forming ability and phylogenetic groups B2 and B1 among UPEC isolates [61, 62]. Moreover, there were no notable distinctions noted in the ratio of biofilm-positive strains between ESBL-positive and ESBL-negative isolates.
On the other hand, blaCTX-M was found to be more prevalent in phylogroups B2 (75.9%) and E (75%), while blaTEM was more frequently detected in phylogroups D (70%) and A (60%). Additionally, the presence of the blaTEM gene was significantly associated with phylogroup D compared to other phylogroups (P = 0.007), which is in line with previous reports [63]. Regarding PMQR genes, our results did not reveal any significant associations between qnrS or qnrB and different phylogroups.
The findings of this study showed that serogroup O25 had the highest frequency, as determined by O antigen. In this regard, serogroup O25 was predominant among adults, while serogroup O1 was predominant among children. Serogroup O1 is primarily associated with capsular K antigens and is linked to extraintestinal infections in humans. It is a major causative factor for UTIs and sepsis in pediatric patients. Regarding the distribution of O-serogroups among different phylogroups, a significantly higher frequency of serogroup O25 was detected among members of phylogroup B2 compared to other phylogroups (P < 0.001). Additionally, serogroups O16, O1, and O15 were more frequently found in phylogroups B1, B2, and D, respectively. These results emphasize the need for action against isolates belonging to phylogroups B2 and D, not only in adults but also in children.
Our findings suggest that non-biofilm-producing E. coli strains exhibit significantly higher levels of fimA gene expression when compared to their biofilm-producing counterparts. Previous studies have also demonstrated that the fimA gene and operon are highly expressed in certain E. coli isolates, whereas the type 1 fimbrial adhesin, fimH, which plays a crucial role in virulence and invasion during murine infection, was found to be expressed in only a limited number of patients. FimH is vital for connecting E. coli with host cell receptors during catheter-associated biofilm formation, and mutations affecting its expression can result in reduced virulence in UPEC [64, 65].
Conclusion
In conclusion, the high fluoroquinolone resistance rates in this study underscore the importance of local resistance monitoring and investigation of underlying mechanisms. Our results reveal the dominance of phylogroups B2 and D as the predominant phylogenetic groups in both adults and children. Additionally, our results indicate that members of phylogroup A exhibit the highest RS. This study further confirms the widespread presence of blaCTX-M, blaTEM, and qnrS among UPEC isolates, which also harbor essential adhesion-associated virulence genes, particularly papA and fimH. Moreover, phylogenetic groups B1 and B2 demonstrate a greater capacity for biofilm production compared to other phylogroups. These study outcomes affirm the heterogeneity and complex genetic backgrounds of UPEC isolates. Consequently, it is imperative to investigate the epidemiological aspects and characterize UPEC isolates across diverse regions and time frames.
Data availability
The datasets used and/or analyzed during the current study are available from the corresponding author on reasonable request.
Abbreviations
- KTPs:
-
Kidney transplant patients
- SD:
-
Standard deviation
- UPEC:
-
Uropathogenic Escherichia coli
- UTIs:
-
Urinary tract infections
- VFs:
-
Virulence factors
- MDR:
-
Multidrug resistant
- EMB:
-
Eosin Methylene Blue
- PCR:
-
Polymerase Chain Reaction
- BHI:
-
Brain Heart Infusion
- AST:
-
Antimicrobial susceptibility testing
- CLSI:
-
Clinical Laboratory Standards Institute
- OD:
-
Optical density
- ESBL:
-
Extended-spectrum beta-lactamase
- DDS:
-
Double-disc synergy
- PMQR:
-
Plasmid-Mediated Quinolone Resistance
- ARGs:
-
Antimicrobial resistance genes
References
Jomehzadeh N, Saki M, Ahmadi K et al (2022) The prevalence of plasmid-mediated quinolone resistance genes among Escherichia coli strains isolated from urinary tract infections in southwest Iran. Mol Biol Rep 49(5):3757–3763. https://doi.org/10.1007/s11033-022-07215-5
Wagenlehner FM, Bjerklund Johansen TE, Cai T et al (2020) Epidemiology, definition and treatment of complicated urinary tract infections. Nat Rev Urol 17(10):586–600
Kammili N, Rani M, Styczynski A et al (2020) Plasmid-mediated antibiotic resistance among uropathogens in primigravid women—Hyderabad. India Plos one 15(5):e0232710
Partridge SR, Kwong SM, Firth N et al (2018) Mobile genetic elements associated with antimicrobial resistance. Clin Microbiol Rev. https://doi.org/10.1128/cmr.00088-17
Pettengill JB, Kase JA, Murray MH (2021) The population genetics, virulence, and public health concerns of Escherichia coli collected from rats within an urban environment. Front Microbiol. https://doi.org/10.3389/fmicb.2021.631761
Clermont O, Christenson JK, Denamur E et al (2013) The Clermont Escherichia coli phylo-typing method revisited: improvement of specificity and detection of new phylo-groups. Environ Microbiol Rep 5(1):58–65
Sadeghi A, Halaji M, Fayyazi A et al (2020) Characterization of plasmid-mediated quinolone resistance and serogroup distributions of uropathogenic Escherichia coli among Iranian kidney transplant patients. Biomed Res Int 2020:2850183. https://doi.org/10.1155/2020/2850183
Vysakh A, Midhun SJ, Jayesh K et al (2018) Studies on biofilm formation and virulence factors associated with uropathogenic Escherichia coli isolated from patient with acute pyelonephritis. Pathophysiology 25(4):381–387. https://doi.org/10.1016/j.pathophys.2018.07.004
Payam B (2017) Uropathogenic Escherichia coli and fimbrial adhesins virulome. In: Tomas J, Agnieszka D, Maria Alicja D-Ś (eds) Urinary tract infection. IntechOpen, Rijeka
Orndorff PE, Falkow S (1984) Organization and expression of genes responsible for type 1 piliation in Escherichia coli. J Bacteriol 159(2):736–744
Wullt B, Bergsten G, Samuelsson M et al (2001) The role of P fimbriae for colonization and host response induction in the human urinary tract. J Infect Dis 183(1):S43–S46
Nasrollahian S, Halaji M, Hosseini A et al (2022) Genetic diversity, Carbapenem resistance genes, and biofilm formation in UPEC isolated from patients with catheter-associated urinary tract infection in North of Iran. Int J Clin Pract 2022:9520362. https://doi.org/10.1155/2022/9520362
Halaji M, Shahidi S, Atapour A et al (2020) Characterization of extended-spectrum β-lactamase-producing uropathogenic Escherichia coli among Iranian kidney transplant patients. Infect Drug Resist 8:1429–1437
Clinical, Institute LS (2022) Performance Standards for Antimicrobial Susceptibility Testing. 32nd ed. Clinical and Laboratory Standards Institute Wayne, PA,
Hojabri Z, Mirmohammadkhani M, Darabi N et al (2019) Characterization of antibiotic-susceptibility patterns and virulence genes of five major sequence types of Escherichia coli isolates cultured from extraintestinal specimens: a 1-year surveillance study from Iran. Infect Drug Resist 12:893–903. https://doi.org/10.2147/idr.s199759
Magiorakos A-P, Srinivasan A, Carey R, et al (2011) Multidrug-resistant, extensively drug-resistant and pandrug-resistant bacteria: an international expert proposal for interim standard definitions for acquired resistance. Clin Microbiol Infect 18:268–281. https://doi.org/10.1111/j.1469-0691.2011.03570.x
Stepanović S, Vukovic D, Holá V et al (2007) Quantification of biofilm in microtiter plates: overview of testing conditions and practical recommendations for assessment of biofilm production by Staphylococci. APMIS 115:891–899. https://doi.org/10.1111/j.1600-0463.2007.apm_630.x
Chen WP, Kuo TT (1993) A simple and rapid method for the preparation of gram-negative bacterial genomic DNA. Nucleic Acids Res 21(9):2260. https://doi.org/10.1093/nar/21.9.2260
Momtaz H, Karimian A, Madani M et al (2013) Uropathogenic Escherichia coli in Iran: serogroup distributions, virulence factors and antimicrobial resistance properties. Ann Clin Microbiol Antimicrob 12:8. https://doi.org/10.1186/1476-0711-12-8
Astley DJ, Spang L, Parnian F et al (2022) A comparative study of the clonal diversity and virulence characteristics of uropathogenic Escherichia coli isolated from Australian and Turkish (Turkey) children and adults with urinary tract infections. Germs 12(2):214–230
Nelson JM, Good E (2015) Urinary tract infections and asymptomatic bacteriuria in older adults. Nurse Pract 40(8):43–48
Alfuraiji N, Al-Hamami A, Ibrahim M et al (2022) Uropathogenic Escherichia coli virulence characteristics and antimicrobial resistance amongst pediatric urinary tract infections. J Med Life 15(5):650–654. https://doi.org/10.25122/jml-2021-0148
FarajzadehSheikh A, Veisi H, Shahin M et al (2019) Frequency of quinolone resistance genes among extended-spectrum β-lactamase (ESBL)-producing Escherichia coli strains isolated from urinary tract infections. Trop Med Health 47:19. https://doi.org/10.1186/s41182-019-0147-8
Goodarzi R, Yousefimashouf R, Sedighi I et al (2022) Detection of adhesion encoding genes, antibacterial susceptibility test and biofilm formation of uropathogenic Escherichia coli isolated from urinary tract infections in children. J Adv Med Biomed Res 30(138):47–53
Rahn DD (2008) Urinary tract infections: contemporary management. Urol Nurs 28(5):333–341
Saint S, Kowalski CP, Kaufman SR et al (2008) Preventing hospital-acquired urinary tract infection in the United States: a national study. Clin Infect Dis 46(2):243–250. https://doi.org/10.1086/524662
Chiu C-C, Lin T-C, Wu R-X et al (2017) Etiologies of community-onset urinary tract infections requiring hospitalization and antimicrobial susceptibilities of causative microorganisms. J Microbiol Immunol Infect 50(6):879–885
Paniagua-Contreras GL, Monroy-Pérez E, Rodríguez-Moctezuma JR et al (2017) Virulence factors, antibiotic resistance phenotypes and O-serogroups of Escherichia coli strains isolated from community-acquired urinary tract infection patients in Mexico. J Microbiol Immunol Infect 50(4):478–485. https://doi.org/10.1016/j.jmii.2015.08.005
Samei A, Haghi F, Zeighami H (2016) Distribution of pathogenicity island markers in commensal and uropathogenic Escherichia coli isolates. Folia Microbiol 61:261–268
Tabasi M, Asadi Karam MR, Habibi M et al (2015) Phenotypic assays to determine virulence factors of uropathogenic Escherichia coli (UPEC) Isolates and their correlation with antibiotic resistance pattern. Osong Public Health Res Perspect 6(4):261–268. https://doi.org/10.1016/j.phrp.2015.08.002
Ghazvini H, Taheri K, Edalati E et al (2019) Virulence factors and antimicrobial resistance in Uropathogenic Escherichia coli strains isolated from cystitis and pyelonephritis. Turk J Med Sci 49(1):361–367. https://doi.org/10.3906/sag-1805-100
Hagos DG, Mezgebo TA, Berhane S et al (2019) Biofilm and hemagglutinin formation: a Hallmark for drug resistant uropathogenic Escherichia coli. BMC Res Notes 12(1):358. https://doi.org/10.1186/s13104-019-4382-1
Manjarrez-Hernandez A, Molina-López J, Gavilanes-Parra S et al (2016) Escherichia coli clonal group A among uropathogenic infections in Mexico City. J Med Microbiol 65(12):1438–1444. https://doi.org/10.1099/jmm.0.000389
Gharavi MJ, Zarei J, Roshani-Asl P et al (2021) Comprehensive study of antimicrobial susceptibility pattern and extended spectrum beta-lactamase (ESBL) prevalence in bacteria isolated from urine samples. Sci Rep 11(1):578
Shapouri Moghaddam A, Arfaatabar M, Tavakol Afshari J et al (2019) Prevalence and antimicrobial resistance of bacterial uropathogens isolated from iranian kidney transplant recipients: a systematic review and meta-analysis. Iran J Public Health 48(12):2165–2176
Akgoz M, Akman I, Ates AB et al (2020) Plasmidic fluoroquinolone resistance genes in fluoroquinolone-resistant and/or extended spectrum Beta-Lactamase-Producing Escherichia coli Strains Isolated from Pediatric and adult patients diagnosed with urinary tract infection. Microb Drug Resist 26(11):1334–1341
Ayobola ED, Oscar WO, Ejovwokoghene EF (2021) Occurrence of plasmid mediated fluoroquinolone resistance genes amongst enteric bacteria isolated from human and animal sources in Delta State. Nigeria AIMS Microbiol 7(1):75–95. https://doi.org/10.3934/microbiol.2021006
Jabalameli L, Beigverdi R, Ranjbar HH et al (2021) Phenotypic and genotypic prevalence of extended-spectrum β-Lactamase-Producing Escherichia coli: a systematic review and meta-analysis in Iran. Microb Drug Resist 27(1):73–86
Motamedifar M, Mohebi S, Hadadi M et al (2020) The prevalence of ESBL and AmpC β-lactamases in uropathogenic isolates of Escherichia coli in a tertiary care hospital in Southwest Iran. Gene Reports 20:100747. https://doi.org/10.1016/j.genrep.2020.100747
Sadeghi M, Mojtahedi A, Nikokar I et al (2023) The emergence of plasmid-encoded oxacillinase and carbapenemase among uropathogenic Escherichia coli (UPEC) isolated from hospitalized patients in the North of Iran. Heliyon 9(4):89
Sadeghi M, Ebrahim-Saraie HS, Mojtahedi A (2022) Prevalence of ESBL and AmpC genes in E coli isolates from urinary tract infections in the north of Iran. New Microbes New Infections 45:100947. https://doi.org/10.1016/j.nmni.2021.100947
Qasemi A, Rahimi F, Katouli M (2022) Clonal groups of extended-spectrum β-lactamase and biofilm producing uropathogenic Escherichia coli in Iran. Pathogens Global Health 116(8):485–497. https://doi.org/10.1080/20477724.2021.2011578
Hansen DS, Schumacher H, Hansen F et al (2012) Extended-spectrum β-lactamase (ESBL) in Danish clinical isolates of Escherichia coli and Klebsiella pneumoniae: prevalence, β-lactamase distribution, phylogroups, and co-resistance. Scand J Infect Dis 44(3):174–181. https://doi.org/10.3109/00365548.2011.632642
Kresken M, Pfeifer Y, Hafner D et al (2014) Occurrence of multidrug resistance to oral antibiotics among Escherichia coli urine isolates from outpatient departments in Germany: extended-spectrum β-lactamases and the role of fosfomycin. Int J Antimicrob Agents 44(4):295–300
Zhu FH, Rodado MP, Asmar BI et al (2019) Risk factors for community acquired urinary tract infections caused by extended spectrum β-lactamase (ESBL) producing Escherichia coli in children: a case control study. Infect Dis 51(11–12):802–809
Rezazadeh M, Baghchesaraei H, Peymani A (2016) Plasmid-mediated quinolone-resistance (qnr) genes in clinical isolates of Escherichia coli collected from several hospitals of Qazvin and Zanjan Provinces. Iran Osong Public Health Res Perspect 7(5):307–312. https://doi.org/10.1016/j.phrp.2016.08.003
Ghaderi RS, Yaghoubi A, Amirfakhrian R et al (2020) The prevalence of genes encoding ESBL among clinical isolates of Escherichia coli in Iran: a systematic review and meta-analysis. Gene Rep 18:100562
Sepp E, Andreson R, Balode A et al (2019) Phenotypic and molecular epidemiology of ESBL-, AmpC-, and carbapenemase-producing Escherichia coli in Northern and Eastern Europe. Front Microbiol 10:2465
Kubone PZ, Mlisana KP, Govinden U et al (2020) Antibiotic susceptibility and molecular characterization of uropathogenic Escherichia coli associated with community-acquired urinary tract infections in urban and rural settings in South Africa. Trop Med Infectious Dis 5(4):176
Mohammed Y, Gadzama GB, Zailani SB et al (2016) Characterization of extended-spectrum beta-lactamase from Escherichia coli and Klebsiella species from North Eastern Nigeria. J Clin Diagnostic Res 10(2):07
Cristea VC, Gheorghe I, Barbu IC et al (2019) Snapshot of phylogenetic groups, virulence, and resistance markers in Escherichia coli uropathogenic strains isolated from outpatients with urinary tract infections in Bucharest Romania. BioMed Res Int 2:9
Nwafuluaku IG, Agbakoba NR, Ushie SN et al (2021) Prevalence and molecular characterization of extended spectrum beta-lactamase producing uropathogenic Escherichia coli in a tertiary health care facility in Anambra State, Nigeria. World J Adv Res Rev 11(3):300–311
Afsharikhah S, Ghanbarpour R, Mohseni P et al (2023) High prevalence of β-lactam and fluoroquinolone resistance in various phylotypes of Escherichia coli isolates from urinary tract infections in Jiroft city. Iran BMC Microbiol 23(1):1–12
Halaji M, Fayyazi A, Rajabnia M et al (2022) Phylogenetic group distribution of Uropathogenic Escherichia coli and related antimicrobial resistance pattern: a meta-analysis and systematic review. Front Cell Infect Microbiol 12:790184. https://doi.org/10.3389/fcimb.2022.790184
Dadi BR, Abebe T, Zhang L et al (2020) Distribution of virulence genes and phylogenetics of uropathogenic Escherichia coli among urinary tract infection patients in Addis Ababa. Ethiopia BMC Infect Dis 20(1):108. https://doi.org/10.1186/s12879-020-4844-z
Javed S, Mirani ZA, Pirzada ZA (2021) Phylogenetic group B2 expressed significant biofilm formation among drug resistant Uropathogenic Escherichia coli. Libyan J Med 16(1):1845444. https://doi.org/10.1080/19932820.2020.1845444
Zhao R, Shi J, Shen Y et al (2015) Phylogenetic Distribution of virulence genes among ESBL-producing Uropathogenic Escherichia coli Isolated from long-term hospitalized patients. J Clin Diagn Res 9(7):01–04. https://doi.org/10.7860/jcdr/2015/13234.6157
Basu S, Mukherjee SK, Hazra A et al (2013) Molecular characterization of Uropathogenic Escherichia coli: nalidixic acid and ciprofloxacin resistance, virulent factors and phylogenetic background. J Clin Diagn Res 7(12):2727–2731. https://doi.org/10.7860/jcdr/2013/6613.3744
Mohsin AS, Alsakini AH, Ali MR (2022) Outbreak of drug resistance Escherichia coli phylogenetic F group associated urinary tract infection. Iran J Microbiol 14(3):341–350. https://doi.org/10.18502/ijm.v14i3.9771
Lin W-H, Wang M-C, Liu P-Y et al (2022) Escherichia coli urinary tract infections: Host age-related differences in bacterial virulence factors and antimicrobial susceptibility. J Microbiol Immunol Infect 55(2):249–256
Nielsen DW, Klimavicz JS, Cavender T et al (2018) The impact of media, phylogenetic classification, and E. coli pathotypes on biofilm formation in extraintestinal and commensal E. coli from humans and animals. Front Microbiol 9:902
Tewawong N, Kowaboot S, Pimainog Y et al (2020) Distribution of phylogenetic groups, adhesin genes, biofilm formation, and antimicrobial resistance of uropathogenic Escherichia coli isolated from hospitalized patients in Thailand. PeerJ 8:e10453
Luo S, Liao C, Peng J et al (2023) Resistance and virulence gene analysis and molecular typing of Escherichia coli from duck farms in Zhanjiang China. Front Cell Infect Microbiol. https://doi.org/10.3389/fcimb.2023.1202013
Hagan EC, Lloyd AL, Rasko DA et al (2010) Escherichia coli global gene expression in urine from women with urinary tract infection. PLoS Pathog 6(11):e1001187. https://doi.org/10.1371/journal.ppat.1001187
Bielecki P, Muthukumarasamy U, Eckweiler D et al (2014) In vivo mRNA profiling of uropathogenic Escherichia coli from diverse phylogroups reveals common and group-specific gene expression profiles. MBio 5(4):01075. https://doi.org/10.1128/mBio.01075-14
Acknowledgements
The authors are very thankful to Babol University of Medical Sciences for the facilities to accomplish the present research project.
Funding
This study was financially funded by the Babol University of Medical Sciences [Grant No. 724134143].
Author information
Authors and Affiliations
Contributions
Conceived and designed the experiments: MR and MH. Performed the experiments: MH, MM, TM, and AP. Analyzed the data: AB and TM. Contributed to the writing of the manuscript: TM, MH, MM and AP. Manuscript revision and English editing: MH and RR. All authors read and approved the final manuscript.
Corresponding authors
Ethics declarations
Conflict of interest
The authors declare that the research was conducted in the absence of any commercial or financial relationships that could be construed as a potential conflict of interest.
Ethical approval
The study was approved by the Research Ethics Committee of Babol University of Medical Sciences (No. IR.MUBABOL.HRI.REC.1401.142.), Babol, Iran. In this study, bacteria isolated from clinical samples in the clinical microbiology laboratory were used. However, all enrolled patients provided informed written consent before entering the study. The parents/legally authorized representatives of the minor UTI patients in the study gave their written informed consent.
Additional information
Publisher's Note
Springer Nature remains neutral with regard to jurisdictional claims in published maps and institutional affiliations.
Supplementary Information
Below is the link to the electronic supplementary material.
Rights and permissions
Springer Nature or its licensor (e.g. a society or other partner) holds exclusive rights to this article under a publishing agreement with the author(s) or other rightsholder(s); author self-archiving of the accepted manuscript version of this article is solely governed by the terms of such publishing agreement and applicable law.
About this article
Cite this article
Talieh Mostaghimi, Pournajaf, A., Bijani, A. et al. Phylogenetic analysis, biofilm formation, antimicrobial resistance and relationship between these characteristics in Uropathogenic Escherichia coli. Mol Biol Rep 51, 327 (2024). https://doi.org/10.1007/s11033-023-09031-x
Received:
Accepted:
Published:
DOI: https://doi.org/10.1007/s11033-023-09031-x